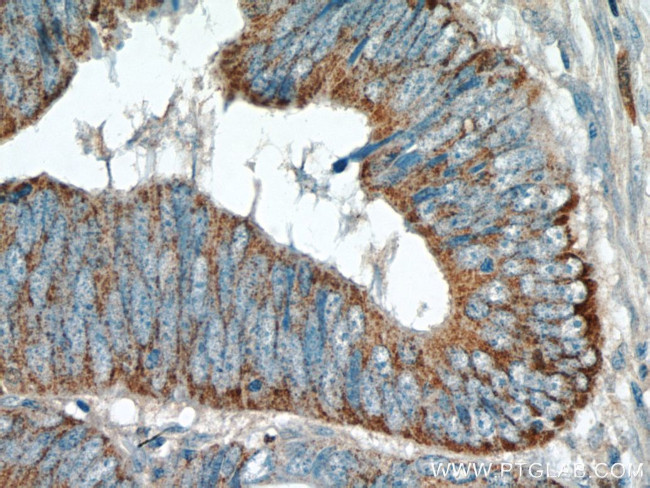
TMEM184A Antibody in Immunohistochemistry (Paraffin) (IHC (P))

Search
Proteintech
TMEM184A Polyclonal Antibody
{{$productOrderCtrl.translations['antibody.pdp.commerceCard.promotion.promotions']}}
{{$productOrderCtrl.translations['antibody.pdp.commerceCard.promotion.viewpromo']}}
{{$productOrderCtrl.translations['antibody.pdp.commerceCard.promotion.promocode']}}: {{promo.promoCode}} {{promo.promoTitle}} {{promo.promoDescription}}. {{$productOrderCtrl.translations['antibody.pdp.commerceCard.promotion.learnmore']}}
产品信息
25989-1-AP
种属反应
宿主/亚型
分类
类型
抗原
偶联物
形式
浓度
规格
纯化类型
保存液
内含物
保存条件
运输条件
产品详细信息
Immunogen sequence: MSNVSGILE TAGVPLVSVN WPQPSPPPAV PAGPQMDHMG NSSQGAPWLF LTSALARGVS GIF (1-62 aa encoded by BC026694)
靶标信息
TMEM184A, a multi-pass transmembrane protein, belongs to the UPF0206 family. While the exact function of TMEM184A remains unclear, it is known to be expressed at high levels in the developing testis. TMEM184A may mediate sex-specific signaling events during Sertoli cell differentiation. The restricted expression of this gene in Sertoli cells suggests a role for the encoded protein in the development and/or continued function of that cell type. Ectopic expression of TMEM184A in female genital ridges resulted in failure of gonocytes to enter meiosis.
仅用于科研。不用于诊断过程。未经明确授权不得转售。
生物信息学
蛋白别名: sexually dimorphic, expressed in male gonads 1; tcag7.540; Transmembrane protein 184A; unnamed protein product
基因别名: SDMG1; SLC51C1; TMEM184A
UniProt ID: (Human) Q6ZMB5
Entrez Gene ID: (Human) 202915